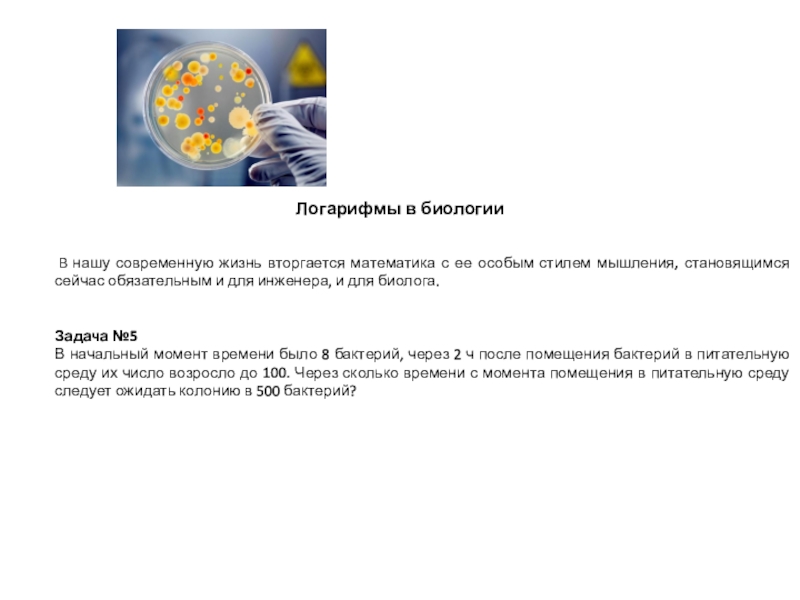

- Главная
- Разное
- Образование
- Спорт
- Естествознание
- Природоведение
- Религиоведение
- Французский язык
- Черчение
- Английский язык
- Астрономия
- Алгебра
- Биология
- География
- Геометрия
- Детские презентации
- Информатика
- История
- Литература
- Математика
- Музыка
- МХК
- Немецкий язык
- ОБЖ
- Обществознание
- Окружающий мир
- Педагогика
- Русский язык
- Технология
- Физика
- Философия
- Химия
- Шаблоны, фоны, картинки для презентаций
- Экология
- Экономика
Презентация, доклад по алгебре и началам анализа 10 класс
Содержание
- 1. Презентация по алгебре и началам анализа 10 класс
- 2. Число 12 считается идеальным числом, оно означает
- 3. anОснование степениПоказатель степених = 2х = - 3х = 0х = - 1
- 4. = 8
- 5. Слайд 5
- 6. ЛОГАРИФМЫ Основное логарифмическое тождество. Простейшие свойства логарифмов.»
- 7. Задачи сегодняшнего урока: Ввести понятие логарифма. Установить
- 8. Слайд 8
- 9. Слайд 9
- 10. Логарифмом числа b по основанию а
- 11. Прочитать логарифмы
- 12. Из истории логарифмов Слово «логарифм» происходит от греческих
- 13. «Изобретение логарифмов, сокращая вычисления нескольких месяцев в труд нескольких дней, словно удваивает жизнь астрономов»П.С. Лаплас
- 14. Основное логарифмическоетождество
- 15. Свойства, следующие из определения
- 16. Десятичный логарифм - это логарифм по основанию10 Обозначение:
- 17. Вычислить:
- 18. 1)log9 81 ; 3)log 31;4)log5 5 ;2)log 5)log 4;6)log47)lg100;8) 9)log64 8
- 19. Слайд 19
- 20. Логарифмы в биологии В нашу современную
- 21. Логарифмы в химии и биофизике
- 22. Логарифмы в географии «Без знания
- 23. Другой пример из расчётов прироста производства древесины.
- 24. Слайд 24
- 25. Раковины многих моллюсков, улиток закручены по логарифмической спирали.
- 26. По логарифмической спирали закручены рога таких млекопитающих,
- 27. По логарифмической спирали очерчены не только раковины.
- 28. В подсолнухе семечки расположены по дугам близкимк
- 29. Почему хищник кружит над добычей? Мы так привыкли,
- 30. Логарифмическая спираль в техникеВ гидротехнике по логарифмической
- 31. Логарифмическая спираль в технике Дело в том,
- 32. Звёзды, шум и логарифмы.Этот заголовок связывает, столь
- 33. По логарифмической спирали закручены и многие галактики,
- 34. Астрономы распределяют звезды по степеням видимой яркости
- 35. Сходным образом оценивается и громкость шума. Вредное
- 36. Шум, громкость которого больше 8 бел, признается
- 37. Великий немецкий поэт Иоганн-Вольфганг Гёте считал логарифмическую
- 38. Вычислите
- 39. Слайд 39
Слайд 1Определение логарифма. Основное логарифмическое тождество. Простейшие свойства логарифмов
Урок подготовила и провела
Егорова Л.Г.- учитель математики МАОУ В(С)Ш №13
Города Тюмени
12.10.2016 г.
Слайд 2Число 12 считается идеальным числом, оно означает мировую гармонию и порядок.
В зодиаке – 12 знаков-животных, на Олимпе – 12 Богов, в сутках 12 часов дня и 12 часов ночи.
Слайд 7Задачи сегодняшнего урока:
Ввести понятие логарифма.
Установить связь между степенью и
Дать определение логарифма.
Записать простейшие свойства логарифмов.
Научиться вычислять логарифмы чисел.
Слайд 10
Логарифмом числа b по основанию а называется показатель степени,
в
Слайд 12Из истории логарифмов
Слово «логарифм» происходит от греческих слов logoz - число
Изобретение логарифмов тесно связано с развитием в XVI веке производства и торговли, астрономии и мореплавания, требовавших усовершенствования методов вычислительной математики.
Все чаще требовалось производить громоздкие действия над многозначными числами, все точнее и точнее должны быть результаты действий. Наибольшие проблемы возникали, как нетрудно понять, при выполнении операций умножения и деления.
Слайд 13«Изобретение логарифмов, сокращая вычисления нескольких месяцев в труд нескольких дней, словно
П.С. Лаплас
Слайд 20Логарифмы в биологии
В нашу современную жизнь вторгается математика
Задача №5
В начальный момент времени было 8 бактерий, через 2 ч после помещения бактерий в питательную среду их число возросло до 100. Через сколько времени с момента помещения в питательную среду следует ожидать колонию в 500 бактерий?
Слайд 21
Логарифмы в химии и биофизике
Для чего же нужны
Думаю, все из нас неоднократно встречались с пометкой pH на моющих средствах.
В химии эту пометку принято называть водородным показателем.
За что же он отвечает?
Водородным показателем pH называется отрицательный десятичный логарифм концентрации ионов водорода.
Переводя на доступный язык, можно сказать, что с помощью водородного показателя определяется уровень кислотности среды.
С помощью логарифмов ученые научились определять точный возраст ископаемых пород и животных. Наиболее распространен Радиоуглеродный анализ.
Слайд 22Логарифмы в географии «Без знания математики нельзя понять ни основ современной
Для планирования развития городов, других населенных пунктов, строительства жилья, дорог, других объектов мест проживания людей, необходимы расчеты – прогнозы на 5, 10, 20 лет вперед.
Покажем, как в таких расчетах применяются логарифмы.
По данным газеты «Зори» от 12 апреля 2011 года из доклада П. Е. Шишкина население в городе Старый Оскол за один год увеличилось с 256100 человек до 257135 человек
Через сколько лет население этого города увеличится в 1,5 раза?
Используются логарифмы и в расчётах, связанных с изменением атмосферного давления при изменении высоты над уровнем моря.
Зависимость давления атмосферы р ( в сантиметрах ртутного столба) от выраженной в километрах высоты h над уровнем моря выражается формулой p=76*2,7-h/8. Вычислим, каким будет атмосферное давление на вершине Эльбруса, высота которой 5,6 км?
Слайд 23
Другой пример из расчётов прироста производства древесины. Задача. Лесной участок содержит
Мы не исчерпали всех примеров применения логарифмов, поскольку это сделать просто невозможно. Логарифмы находят самое широкое применение и при обработке результатов тестирований в психологии и социологии , в составлении прогнозов погоды и т.п.
Слайд 26
По логарифмической спирали закручены рога таких млекопитающих, как архары (горные козлы),
Можно сказать, что эта спираль является математическим символом соотношения формы и роста.
Слайд 27По логарифмической спирали очерчены не только раковины. Один из распространенных пауков,
Слайд 28В подсолнухе
семечки расположены
по дугам близким
к логарифмическим
спиралям.
Особенности логарифмической спирали
Слайд 29Почему хищник кружит над добычей?
Мы так привыкли, что хищник кружит над
Тайна того, почему хищные птицы в большинстве случаев летают именно по спирали, была открыта американцем Тукером. Согласно его заявлению, они делают это, чтобы максимально использовать их острое “поперечное” зрение.
Слайд 30Логарифмическая спираль в технике
В гидротехнике по логарифмической спирали изгибают трубу, подводящую
Пропорциональность длины дуги спирали разности длин радиус – векторов используют при проектировании зубчатых колес с переменным передаточным числом.
Слайд 31Логарифмическая спираль в технике
Дело в том, что в технике часто
Слайд 32Звёзды, шум и логарифмы.
Этот заголовок связывает, столь казалось бы, несоединимые вещи.
Слайд 33По логарифмической спирали закручены и многие галактики, в частности Галактика, которой
Галактика млечный путь - типичная спиральная галактика.
Слайд 34Астрономы распределяют звезды по степеням видимой яркости на светила первой, второй,
Физическая яркость звезд составляет геометрическую прогрессию со знаменателем 2,5. Поэтому «величина» звезды представляет собой не что иное, как логарифм ее
физической яркости. Оценивая видимую яркость звезд, астроном оперирует с таблицей логарифмов, составленной по основанию 2,5
Слайд 35Сходным образом оценивается и громкость шума.
Вредное влияние промышленных шумов на
Громкость шума, выраженная в белах, равна десятичному логарифму его физической силы.
Рассмотрим несколько примеров:
тихий шелест листьев оценивается в 1 бел;
громкая разговорная речь — в 6,5 бела;
рычанье льва — в 8,7 бела;
удары молотка о стальную плиту - в 11 бел;
самое шумное место – Ниагарский водопад – в 9 бел.
Отсюда следует, что по силе звука разговорная речь превышает шелест листьев в 316 000 раз;
Львиное рычанье сильнее громкой разговорной речи в 158 раз.
Слайд 36Шум, громкость которого больше 8 бел, признается вредным для человеческого организма.
Случайность ли то, что при оценке видимой яркости светил и при изменении громкости шума мы имеем дело с логарифмической зависимостью; между величиной ощущения и порождающего его раздражения?
Нет, ученые пришли к выводу о том, что организм как бы «логарифмирует» полученные им раздражения.
Здесь действует так называемый «психофизический закон Фехнера»:
величина ощущения пропорциональна логарифму величины раздражения
Как видим, логарифмы вторгаются и в область психологии
Слайд 37Великий немецкий поэт Иоганн-Вольфганг Гёте считал логарифмическую спираль даже
математическим символом жизни
1749-1833 г.г.